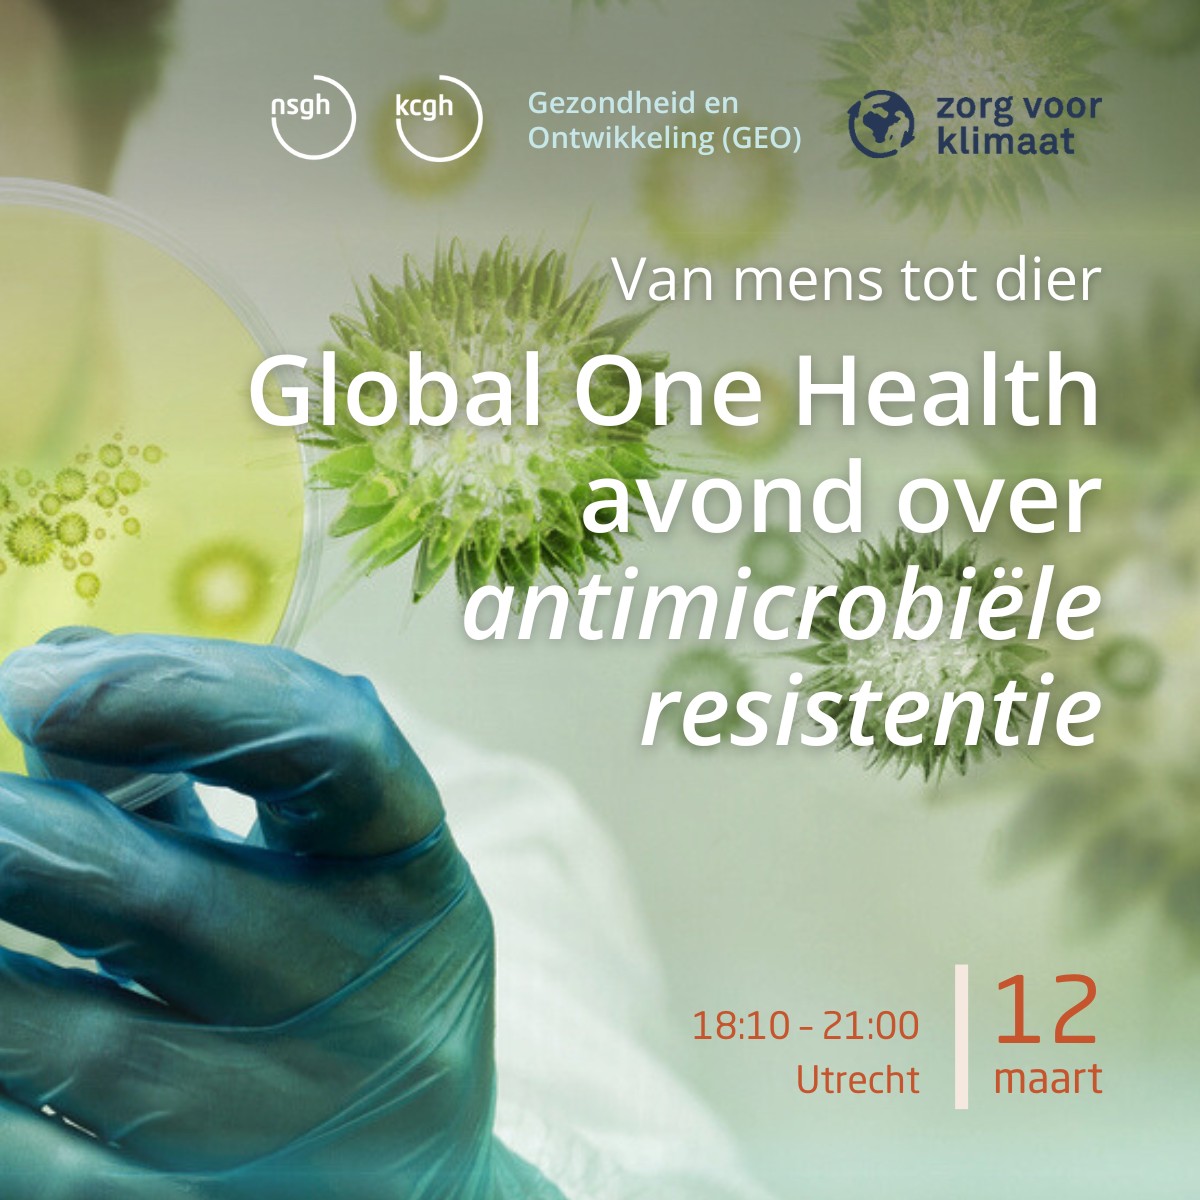

Bacteriën die niet meer reageren op antibiotica: een sluipend gevaar dat wereldwijd levens kost. De NSGH-werkgroepen Zorg voor Klimaat en GEO nodigen je uit voor een avond waarin we de impact van antimicrobiële resistentie (AMR) vanuit mondiaal perspectief onder de loep nemen én op zoek gaan naar oplossingen.
Volgens een grootschalige wereldwijde analyse gepubliceerd in The Lancet, was bacteriële resistentie in 2019 direct verantwoordelijk voor 1,27 miljoen sterfgevallen en droeg het bij aan nog eens 4,95 miljoen sterfgevallen wereldwijd.¹
AMR treft landen in alle regio’s en inkomensgroepen, en de gevolgen worden verergerd door armoede en ongelijkheid. Misbruik en overmatig gebruik van antimicrobiële middelen bij mensen, dieren én in de landbouw vormen belangrijke oorzaken van dit probleem.
Toch willen we tijdens deze avond niet alleen stilstaan bij de dreiging, maar juist ook bij handelingsperspectieven en hoopvolle initiatieven vanuit de praktijk.
Op het programma staan een dierenarts deelt haar ervaringen met het terugdringen van antibioticagebruik in de veehouderij, onder andere in India; een medewerker van Artsen zonder Grenzen vertelt over de gevolgen van AMR bij de behandeling van oorlogsgewonden in conflictgebieden zoals Oekraïne; en een interactieve AMR pubquiz om je kennis te testen én bij te leren.
Deze avond is bedoeld voor iedereen geïnteresseerd in mondiale en duurzame gezondheid. AMR vraagt om samenwerking over sectoren heen – van mens tot dier, van landbouw tot leefomgeving.
1. Antimicrobial Resistance Collaborators. (2022). Global burden of bacterial antimicrobial resistance in 2019: a systematic analysis. The Lancet; 399(10325): P629-655. DOI: https://doi.org/10.1016/S0140-6736(21)02724-0
Programma
| 18:10 | Welkom met soep, broodje en salade |
| 18:40 | MSF’s approach to AMR Mohammed Khalife |
| 19:15 | Natural lifestocking: A strategy for improving livestock health as an integrated part of AMR reduction and agro-ecology Katrien van ‘t Hooft |
| 19:45 | Pauze |
| 20:00 | AMR Pubquiz |
| 20:40 | Nabespreking en afsluiting |
Sprekers

Mohamad Khalife, MD is internist en infectioloog met een focus op antimicrobiële resistentie. Hij werkt voor Artsen zonder Grenzen (MSF) als lid van de Manson Unit in Londen, waar hij AMR-beleid en antibioticastewardship ondersteunt in humanitaire contexten wereldwijd. Hij combineert praktijkgerichte infectiezorg met onderzoek, monitoring en bewustwording rond AMR.

Dr. Katrien van ’t Hooft is dierenarts en oprichter van Dutch Farm Experience, met meer dan 25 jaar ervaring in duurzame melkveehouderij wereldwijd. Ze is directeur van de Foundation for Natural Livestock Farming (NLF), een internationale samenwerking met o.a. India, Ethiopië en Oeganda. De NLF-aanpak laat positieve effecten zien op diergezondheid, antibioticareductie, voedselveiligheid en milieu.